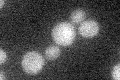
YKR069W
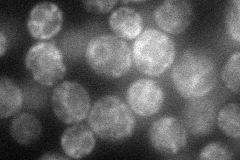
YKR069W
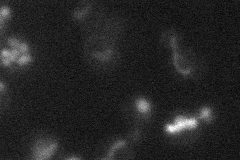
YKR069W
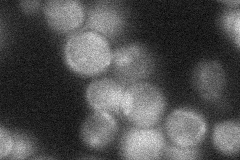
YKR069W
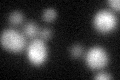
YKR069W

View description
S-adenosyl-L-methionine uroporphyrinogen III transmethylase, involved in the biosynthesis of siroheme, a prosthetic group used by sulfite reductase; required for sulfate assimilation and methionine biosynthesis
Localization:
Intensity:
Fold change:
Significance:
-
C’ GFP library in SD
below threshold16.61 -
N' NOP1pr-GFP in SD
ER53.4823 -
N' TEF2pr-mCherry in SD
vacuole8.40765 -
N' NATIVEpr-GFP in SD
nucleus21.8929 -
N' TEF2pr-VC and Cyto-VN in SD

#N/A0 -
C’ GFP library in SD+DTT
cytosol16.711No -
C’ GFP library in SD+H2O2

cytosol14.480.87No -
C’ GFP library in Starvation Media

cytosol17.961.08No -
C’ GFP library on the background of Pup2-DaMP

below threshold -
C’ GFP library on the background of CCT mutant

below threshold16.95061.02043No
